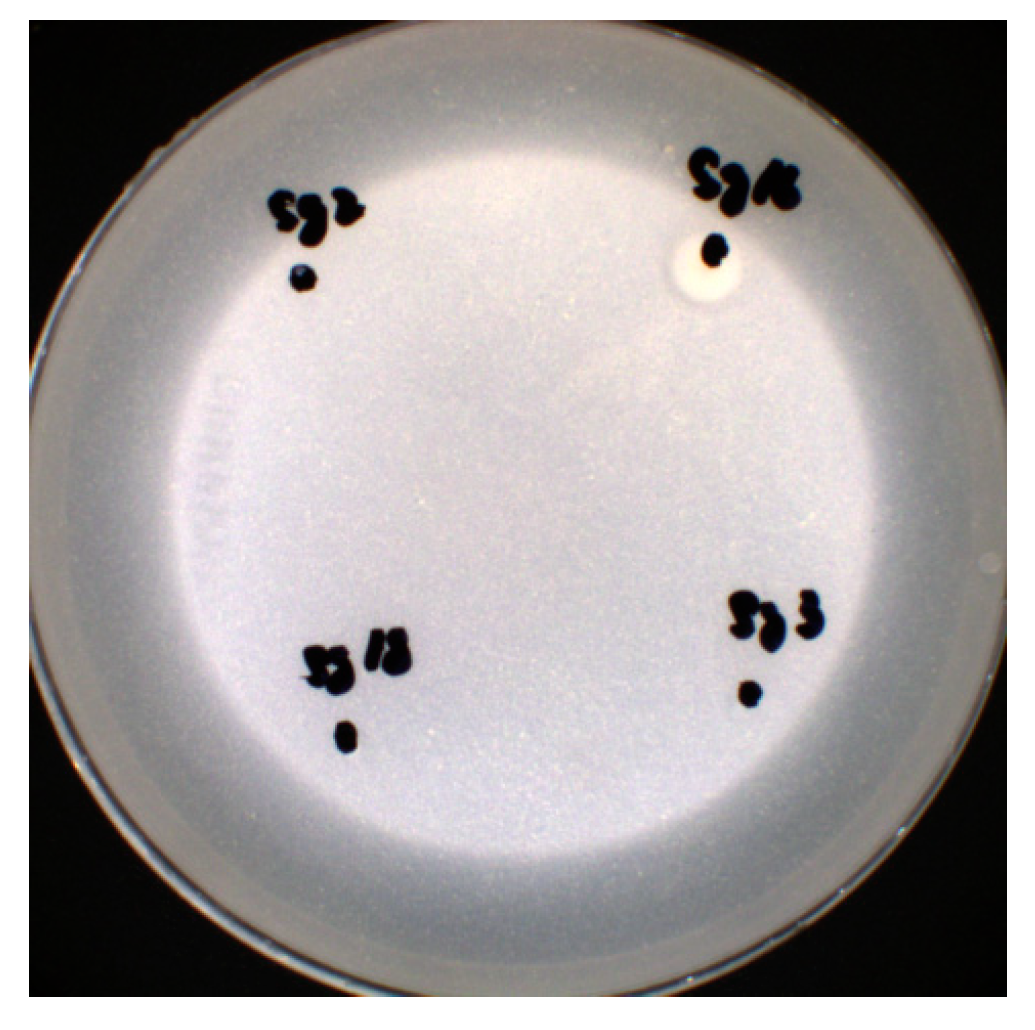
Microbiolres 15 00091 g007

Examining the Diversity of Rhizosphere Soil Bacterial Communities and Screening of Growth-Promoting Bacteria from the Rhizosphere Soil of Haloxylon ammodendron in Xinjiang
Abstract
1. Introduction
2. Materials and Methods
2.1. Test Materials
2.2. Analysis of Bacterial Microbial Diversity in Rhizome Soil of Haloxylon ammodendron via High-Throughput Sequencing
2.2.1. Data Processing of High-Throughput Sequencing Information
2.2.2. Data Analysis
2.3. Separation and Purification of Rhizome Soil Strains of Haloxylon Ammodendron
2.4. Analysis of 16S rDNA Sequence of Rhizosphere Soil Bacteria
2.5. Growth-Promoting Bacteria Screening
2.5.1. Screening of Phosphorus-Solubilizing Bacteria
2.5.2. Screening of Potassium-Solubilizing Bacteria
2.5.3. Nitrogen-Fixing Bacteria Screening
2.5.4. Screening of Iron-Producing Carrier Strains
3. Results
3.1. In-Depth Analysis of Sequencing
3.2. Comparative Analysis of Phylum Level
3.3. Comparative Analysis of Genus Level
3.4. Species Distribution of Rhizosphere Soil Bacteria in 2-Year and 5-Year Haloxylon ammodendron Soil at Taxonomic Level
3.5. OTU Clustering
3.6. Diversity of Rhizosphere Bacterial Microbial Community α
3.7. PCA
3.8. Analysis of 16Sr DNA Sequence in Rhizosphere Soil Bacteria of Haloxylon ammodendron
3.9. Screening of Growth-Promoting Bacteria in the Rhizosphere soil of Haloxylon ammodendron
3.9.1. Phosphorus Solubilization Capacity
3.9.2. Potassium Capacity
3.9.3. Nitrogen-Fixing Capacity
3.9.4. Iron-Bearing Capacity
4. Discussion
5. Conclusions
Supplementary Materials
Author Contributions
Funding
Institutional Review Board Statement
Informed Consent Statement
Data Availability Statement
Acknowledgments
Conflicts of Interest
References
- Tang, X.Y. Seedling rearing and efficient cultivation technology of Haloxylon ammodendron. Mod. Hortic. 2019, 46, 59–61. [Google Scholar]
- Zhang, W.J. Effects of different afforestation methods on the growth of Haloxylon ammodendron. Chin. For. By-Prod. 2023, 90-91+96. [Google Scholar]
- Li, H.P. Characterization and Mechanism Analysis of Phosphorus-Solubilizing Bacteria in the Rhizosphere of Haloxylon ammodendron and Spruce. Bachelor’s Thesis, Lanzhou University, Lanzhou, China, 2023. [Google Scholar]
- Zou, T.; Li, Y.; Xu, H.; Xu, G.Q. Responses to precipitation treatment for Haloxylon ammodendron growing on contrasting textured soils. Ecol. Res. 2010, 25, 185–194. [Google Scholar] [CrossRef]
- Song, Q. Study on the Mechanism of Stress Resistance of Plant Rhizosphere Growth-Promoting Bacteria on Pinus Camphor Seedlings. Bachelor’s Thesis, Northeast Forestry University, Harbin, China, 2021. [Google Scholar]
- Meng, J.Y.; Zhang, T.T.; Yang, L.H. Isolation of phosphorus solubilizing bacteria from the rhizosphere of Haloxylon ammodendron and its ability to decompress organic phosphorus. Tianjin Agric. Sci. 2021, 27, 1–4. [Google Scholar]
- Zhao, X.; Gao, H.L.; Long, J.M.; Liu, Y.X.; Li, X.; He, X.L. Spatial and temporal distribution of endophytic fungi and other microorganisms in the roots of Haloxylon ammodendron in the northwest sandy region and their response to rhizosphere soil environment. Chin. J. Bacteriol. 2017, 40, 2716–2734. [Google Scholar]
- Wang, L.; Song, W.; Liu, X.X.; Qin, S.Y.; Zhai, W.J. the research progress of biological active ingredients and effect. J. Food Sci. Technol. 2023, 13, 208–214. [Google Scholar]
- Liu, Y.Y.; Bao, L.M.; Wei, Y.L.; Zi, F.T.; Tan, Y. Continuous cropping notoginseng rhizosphere soil since the toxic material and research progress of microbial interactions. J. Tradit. Chin. Med. 2022, 242–247. [Google Scholar]
- Yu, Q.L.; Zhao, Z.R.; Liu, L. Research progress of rhizosphere microbial community function and regulation. Chin. J. Microbiol. 2019, 43, 1–8. [Google Scholar]
- Mou, J.P.; Teng, B.X.; Shi, Z.F.; Hen, X.W.; Lai, J.; Zhu, L.; Xiao, J.; Zeng, X.M. Study on rhizosphere soil microbial community structure and diversity in Astragalus planting area of Gansu Province based on high-throughput sequencing. Wild Plant Resour. China 2019, 41, 15–24. [Google Scholar]
- Zhao, L.Y.; Suo, S.Z.; Zhao, Q.; Yao, D.; Li, H.P.; Christopher, R.; Zhang, J.L. Effects of Rhizopause promoting Bacteria (PGPR) fertilizer on yield, quality and soil characteristics of tomato. J. Gansu Agric. Univ. 2022, 57, 42–51+57. [Google Scholar]
- Li, Y.B.; Li, Y.L.; Guan, G.H.; Chen, S.F. Screening and identification of plant rhizosphere growth-promoting bacteria and their effect on wheat reduction and increase. Chin. J. Agric. Biotechnol. 2019, 28, 1471–1476. [Google Scholar]
- Gou, J.Y. Characteristics and Physiological Regulation of Haloxylon ammodendron Rhizosphere Growth-Promoting Bacteria on Grass Growth of Three Legumes. Bachelor’s Thesis, Lanzhou University, Lanzhou, China, 2019. [Google Scholar]
- Baudoin, E.; Benizri, E.; Guckert, A. Impact of artificial root exudates on the bacterial community structure in bulk soil and maize rhizo sphere. Soil Biol. Biochem. 2003, 35, 1183–1192. [Google Scholar] [CrossRef]
- Cao, Y.F.; Li, Y.; Li, C.H.; Lü, G.H. Relationship between presence of the desert shrub Haloxylon ammodendron and microbial communities in two soils with contrasting textures. Appl. Soil Ecol. 2016, 103, 93–100. [Google Scholar] [CrossRef]
- Shen, L.; Xu, R.; Liu, S.; Xu, C.Q.; He, N.; Liu, T.N.; Chen, J. Microbial species and community structure in rhizosphere soil of Cistanciola Deserticola Haloxylon Ammodendron. Acta Ecol. Sin. 2016, 36, 3933–3942. [Google Scholar]
- Zhang, D.D.; Zhao, J.F.; Xie, S.Y.; Hu, F.W.; Wu, Q.; Zhou, X.Q. Analysis of microbial diversity in maize based on high-throughput sequencing. Chin. J. Food Sci. 2023, 23, 305–314. [Google Scholar]
- Felšöciová, S.; Kowalczewski, P.Ł.; Krajčovič, T.; Dráb, Š.; Kačániová, M. Quantitative and qualitative composition of bacterial communities of malting barley grain and malt during long-term storage. Agronomy 2020, 10, 1301. [Google Scholar] [CrossRef]
- EL-KHOLY, M.M.; KAMEL, R.M. Performance analysis and quality evaluation of wheat storage in horizontal silo bags. Int. J. Food Sci. 2021, 2021, 1248391. [Google Scholar] [CrossRef]
- Wang, Y.M.; Fu, J.H.; Qin, X.Z.; Wang, J.; Ruan, W.W.; Cui, F.Z.; Nie, H.L. Isolation, screening and growth promoting characteristics of growth-promoting bacteria from mossy crusty soil in Gurbantunggut Desert. J. Microbiol. 2019, 43, 47–57. [Google Scholar]
- Zheng, Y.Q.; Du, G.Z.; LI, Y.F.; Chen, B.; Li, Z.Y.; Xiao, G.L. Isolation and identification of intestinal bacteria of potato tuber moth and their effect on degradation of plant derived macromolecular compounds. J. Environ. Entomol. 2017, 39, 525–532. [Google Scholar]
- Jin, L.Y.; Lu, J.J.; Feng, Y.H.; Zhang, Q.Y.; Wu, H.; Li, R.D.; Huang, W.; Lan, C.H.; Tian, B.Y. Screening, identification and phylogenetic analysis of endophytic nitrogen-fixing bacteria in tomato with root knot nematode disease. Fujian Agric. Sci. Technol. 2020, 51, 46–51. [Google Scholar]
- Chen, Z.Y.; Liu, J.; Yang, X.P.; Liu, M.; Wang, Y.; Zhang, Z.B.; Zhu, D. Community composition and diversity of culturable endophytic bacteria from wild rice in Dongxiang. Biodiv. Sci. 2019, 27, 1320–1329. [Google Scholar]
- Du, L.; Wang, S.P.; Chen, G.; Hong, J.; Huang, X.; Zhang, L.H.; Ye, L.X.; Lian, Z.C.; Zhang, G.Y. Screening, identification and phosphorus solubilization capacity of a highly efficient phosphorus solubilizing bacterium. China Soil Fertil. 2017, 23, 136–141. [Google Scholar]
- Gao, C.; Huang, S.F.; Hu, L.; Wang, Z.; Cao, Y.L.; Tan, Z.Y. Diversity and growth promotion of endophytic bacteria in wild rice Niwala. Chin. J. Appl. Environ. Biol. 2018, 24, 6–9. [Google Scholar]
- Li, P.G. Screening, Identification and Effect of Rhizosphere Growth-Promoting Bacteria in Potato and Tomato. Bachelor’s Thesis, Shandong Agricultural University, Tai’an, China, 2020. [Google Scholar]
- Wang, R.L.; Li, J.; Wang, C.; Liu, H.H.; Lu, X.Y.; Tian, Y. Screening, identification and optimization of growth conditions of an autogenous nitrogen-fixing bacterium. Chin. J. Biol. 2022, 39, 69–73. [Google Scholar]
- Yu, S.F.; Ding, Y.Q.; Yao, L.T.; Du, Z.B.; Zhu, P.L.; Du, B.H. Isolation, identification and drug resistance analysis of a rhizospheric ferritis-producing strain. Biotechnol. Commun. 2008, 19, 701–703. [Google Scholar]
- Wang, M.J.; Zheng, T.J. Microbial community structure and selection of growth-promoting bacteria in rhizosphere soil of blueberry. Southwest Chin. J. Agric. Sci. 2019, 36, 983–991. (In Chinese) [Google Scholar]
- Vandenkoomhuye, P.; Quaiser, A.; Duhamel, M.; Le Van, A.; Dufresne, A. The importance of the microbiome of the plant holobiont. Phytologist 2015, 206, 1196–1206. [Google Scholar] [CrossRef] [PubMed]
- Li, Y.; Li, Y.; Yang, J.L.; Wang, X.L.; Hu, Z.D. Effects of increased ultraviolet radiation on microbial population in spring wheat rhizosphere soil. Chin. J. Environ. Sci. 1999, 19, 157–160. [Google Scholar]
- Luo, M.; Shan, N.N.; Wen, Q.K.; Pan, B.R. Microbial characteristics of rhizosphere soil of several sand-fixing plants. Chin. J. Appl. Environ. Biol. 2002, 6, 618–622. [Google Scholar]
- Wang, A.L.; Ma, R.; Ma, Y.J.; Lv, Y.X. Prediction of soil bacterial community structure and function in the artificial Haloxylon ammodendron forest in the transition zone of Minqin desert oasis. Environ. Sci. 2024, 45, 508–519. [Google Scholar]
- Stevenson, A.; Hallsworth, J.E. Water and temperature relations ofsoil Actinobacteria. Environ. Microbiol. Rep. 2014, 6, 744–755. [Google Scholar] [CrossRef] [PubMed]
- Zheng, J.; Chen, J.; Pan, G.; Wang, G.; Liu, X.; Zhang, X.; Li, L.; Bian, R.; Cheng, K.; Zheng, J. A long-term hybrid poplar plantation on cropland reduces soil organic carbon mineralization and shifts microbial community abundance and composition. Appl. Soil Ecol. 2017, 111, 94–104. [Google Scholar] [CrossRef]
- O’donnell, A.G.; Seasman, M.; Macrae, A.; Waite, I.; Davies, J.T. Plants and fertilisers as drivers of change in microbial community structure and function in soils. Plant Soil 2001, 232, 135–145. [Google Scholar] [CrossRef]
- Li, H.R. Analysis of Rhizosphere Culturable Bacteria Diversity of the Xerophyte Haloxylon ammodendron. Bachelor’s Thesis, Lanzhou University, Lanzhou, China, 2016. [Google Scholar]
- Zhang, R.M.; Zhang, D.; Bai, J.; Chen, H.W.; Gao, Y. Analysis of components of root exudates of Haloxylon ammodendron at different seedling ages. Acta Bot. Sin. 2006, 26, 2150–2154. [Google Scholar]
- Luan, L.Y.; Fang, Y.L.; Song, S.R.; Zhang, Z.W.; Wei, Q.X.; Cheng, B.S.; Qu, Y.P.; Zhou, Y. Study on the number of microorganisms in rhizosphere and root zone of wine grapes at different tree ages and different soil depths. J. Northwest For. Coll. 2009, 24, 37–41. [Google Scholar]
- Hu, L.; Jin, X.Y.; Li, J.Y.; Li, M.; Ma, L.; Liu, J.L. Effects of culturable Bacillus on seed germination and seedling growth in desert biological soil crust. J. North China Agric. Sci. 2019, 34, 143–152. [Google Scholar]
- Liu, S.C.; Yang, J.C.; Ma, L.H.; Zhang, C.Y.; He, Y.Q.; Pu, L.H. Effect of Bacillus amylolyticus B9601-Y2 on maize growth and yield. Maize Sci. 2010, 18, 78–82, 85. [Google Scholar]
- Jiang, H.H.; Li, J.Q.; Chen, G.; Wang, T.; Chi, X.Y.; Qi, P.S. Research progress of phosphorus solubilizing microorganisms and their application in saline-alkali soil. Soil Sci. 2019, 53, 1125–1131. [Google Scholar]

| Component | Kingdom | Phylum | Class | Order | Family | Genus | Species |
|---|---|---|---|---|---|---|---|
| Sg2 | 1 | 45 | 109 | 288 | 451 | 826 | 404 |
| Sg5 | 1 | 53 | 139 | 345 | 555 | 1062 | 513 |
| Group | Chao1 | Dominance | Goods_Coverage | OTU | Pielou_e | Shannon | Simpson |
|---|---|---|---|---|---|---|---|
| sg2 | 1720.825 | 0.0237 | 0.998 | 12,206 | 0.783 | 8.360 | 0.977 |
| sg5 | 1745.883 | 0.0157 | 0.998 | 14,053 | 0.791 | 8.470 | 0.984 |
| Strain Number | Colony Diameter (d)/cm | Hydrolytic Ring Diameter (D)/cm | Solubility Index (D/d) |
|---|---|---|---|
| Sg16 | 0.43 | 0.68 | 1.58 |
| Sg21 | 0.59 | 0.73 | 1.23 |
| Ss4 | 0.47 | 0.63 | 1.34 |
| Strain Number | Colony Diameter (d)/cm | Hydrolysis Circle Diameter (D)/cm | Solubility Index (D/d) |
|---|---|---|---|
| Sg9F | 0.17 | 1.18 | 6.94 |
| Sg1 | 0.41 | 0.64 | 1.56 |
Disclaimer/Publisher’s Note: The statements, opinions and data contained in all publications are solely those of the individual author(s) and contributor(s) and not of MDPI and/or the editor(s). MDPI and/or the editor(s) disclaim responsibility for any injury to people or property resulting from any ideas, methods, instructions or products referred to in the content. |
© 2024 by the authors. Licensee MDPI, Basel, Switzerland. This article is an open access article distributed under the terms and conditions of the Creative Commons Attribution (CC BY) license (https://creativecommons.org/licenses/by/4.0/).
Share and Cite
Wang, X.; Chen, Y.; Wang, Z.; Luo, W.; Zhou, J.; Xin, X.; Guo, R.; Zhu, Q.; Wang, L.; Song, S. Examining the Diversity of Rhizosphere Soil Bacterial Communities and Screening of Growth-Promoting Bacteria from the Rhizosphere Soil of Haloxylon ammodendron in Xinjiang. Microbiol. Res. 2024, 15, 1346-1358. https://doi.org/10.3390/microbiolres15030091
Wang X, Chen Y, Wang Z, Luo W, Zhou J, Xin X, Guo R, Zhu Q, Wang L, Song S. Examining the Diversity of Rhizosphere Soil Bacterial Communities and Screening of Growth-Promoting Bacteria from the Rhizosphere Soil of Haloxylon ammodendron in Xinjiang. Microbiology Research. 2024; 15(3):1346-1358. https://doi.org/10.3390/microbiolres15030091
Chicago/Turabian StyleWang, Xuejing, Yong Chen, Zeyu Wang, Wenfang Luo, Junhui Zhou, Xiaoyan Xin, Rui Guo, Qingyue Zhu, Lili Wang, and Suqin Song. 2024. "Examining the Diversity of Rhizosphere Soil Bacterial Communities and Screening of Growth-Promoting Bacteria from the Rhizosphere Soil of Haloxylon ammodendron in Xinjiang" Microbiology Research 15, no. 3: 1346-1358. https://doi.org/10.3390/microbiolres15030091
APA StyleWang, X., Chen, Y., Wang, Z., Luo, W., Zhou, J., Xin, X., Guo, R., Zhu, Q., Wang, L., & Song, S. (2024). Examining the Diversity of Rhizosphere Soil Bacterial Communities and Screening of Growth-Promoting Bacteria from the Rhizosphere Soil of Haloxylon ammodendron in Xinjiang. Microbiology Research, 15(3), 1346-1358. https://doi.org/10.3390/microbiolres15030091






